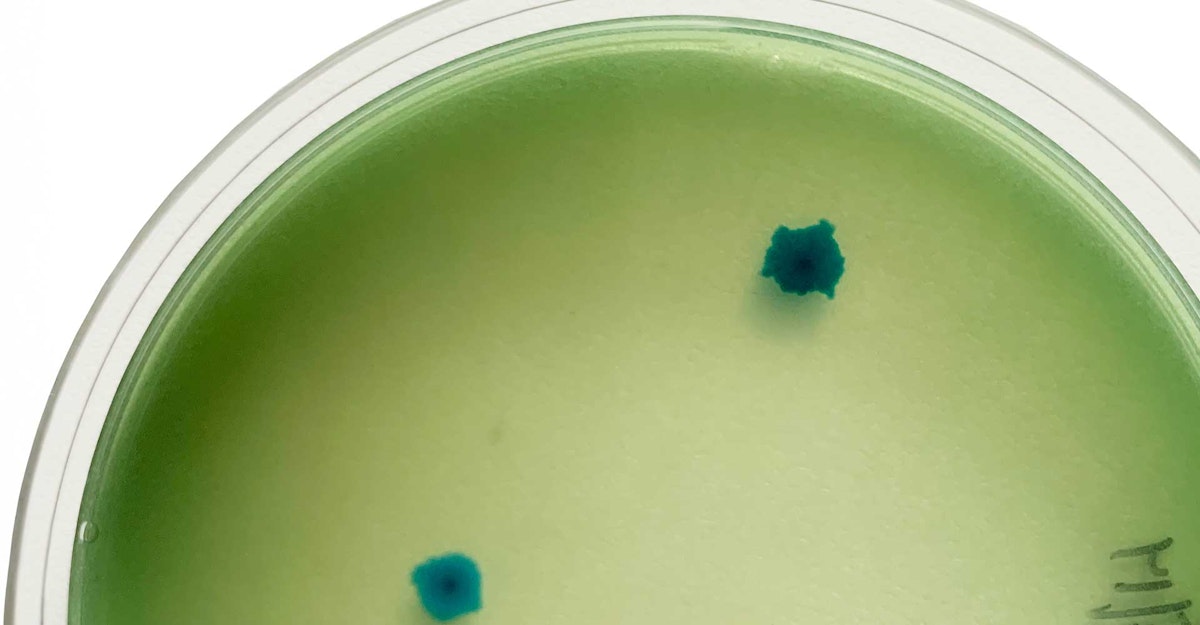

Among all the different types of bacteria that can infect a beer, Bacillus is one of the lesser-known, less-discussed offenders, despite it being pervasive throughout the brewery. Luckily, it’s also not as detrimental as some of the other usual suspects.
Note that in this context we’re not talking about Lactobacillus—a more persistent microbe with which craft brewers tend to be familiar, whether you’re using it intentionally for acidification or trying to avoid it at all costs.
Bacillus, meanwhile, is unlikely to cause off-flavors in your finished beers—I’ll explain why below—yet it is widespread around the brewery, especially during the warmer summer months. As with all microbes that affect brewing, you should be aware of Bacillus and know when it could become an issue.
What Is Bacillus?
Before we go further, let’s summarize the technical details. Bacillus survives in aerobic environments—that is, in the presence of oxygen. It is also:
- gram-positive, meaning it’s easy to test for it
- catalase-positive, producing an enzyme that resists oxidation and breaks down hydrogen peroxide
- oxidase-variable, which is mostly relevant to testing
- able to form endospores in single or paired rods
Now, on to the essential information: What does the existence of Bacillus mean for the brewer and the beer? The first thing to know is that, as brewers, you come into contact with Bacillus all the time. It often occurs naturally on the surfaces of raw materials, including hops and malt. It’s generally found all over the brewing environment, and it can manifest at any stage in the brewing process.
Because Bacillus is commonly found on the surface of hops and pellets, its growth is common in dry-hopped beers. However, there’s good news: It’s not capable of surviving in finished beer. Bacillus is sensitive to hops, low pH levels, and any amount of alcohol. If you happen to discover it early in the fermentation process, there’s a good chance that it won’t be around by the time you crash the beer.
However, although it doesn’t grow in finished beer, it is heat tolerant, so it thrives in unhopped wort. Under those conditions—maybe it’s taking longer than usual to sparge, or there is a delay in starting the boil—Bacillus is capable of producing lactic acid. That’s when it’s useful to remember the bacterium’s sensitivity to hops: If you happen to have hot wort sitting around for a while, throwing some hops in will help prevent further growth of Bacillus. Compounds in those hops can break down the cell membranes of the bacterium, inhibiting active transport across the membranes, essentially shutting down any Bacillus that is present.
How to Test for It
More good news: It’s easy to test for Bacillus. Because it grows quickly on LMDA+ (Lee’s Multi-Differential Agar) media and is aerobic, there is no need for a CO2 chamber. Plating and placing in an incubator at 86°F (30°C) is all it takes to encourage growth within 24 to 48 hours.
It presents as flat colonies that vary from dark green to blue-green in color; once you have growth on your plate that looks like that, you can perform a Gram stain and catalase test to confirm. Note that because Bacillus is oxidase-variable, the oxidase test can give mixed results and requires more involved equipment, so it’s not recommended for identification in this scenario.
Preventive testing is always a good practice to stay ahead of any microbial infections, so testing from heat-exchanger samples can be useful in making sure your wort is free of this bacterium.
Also, testing before and after dry-hop additions can give you some insight into when exactly your Bacillus growth may be happening. If you continue to see a strong manifestation at the end of fermentation and after packaging, you should continue to test throughout the shelf life of the beer to confirm that the bacterium is dying off with exposure to alcohol and in the absence of oxygen.
How to Prevent It
Compared to the more persistent Lactobacillus, your typical Bacillus is relatively easy to fight in the brewery. The most important thing is to avoid letting hot wort sit for too long without exposure to hops, so you can prevent growth early in the brewing process.
While its impact on flavor is minimal, Bacillus is not something you’d want to encourage in pale lagers or other lighter, more delicate beers. If you find the heavy presence of Bacillus in a fermentor, it’s a good idea to do a more intense cleaning before transferring more wort or beer into it.
The same goes for brite tanks and canning lines. Anything in the brewery that is exposed to air has the potential to send this bacterium into a fermentor; good cleaning practices can prevent this transfer from happening. Making sure that your rinse water is up to temperature and getting enough contact time with parts and vessels will give the beer a better chance of clearing out those endospores if they happen to take hold in your brewery.
While Bacillus is relatively harmless compared to other bacteria, it’s not something you want running rampant through your brewery. Keeping up with good cleaning and testing practices will give you a leg up in making sure that you’re producing clean and consistent beers.
About Those Tests … Will You Pass?
LMDA+
Lee’s Multi-Differential Agar+ tests for the presence of bacteria in beer or the brewery environment. This medium allows for growth of both wort-spoiling bacteria and beer-spoiling bacteria. And, what’s the plus for? This form of media includes a protein synthesis inhibitor called cycloheximide to prevent the growth of yeast. This way, only bacteria will grow.
Gram Stain
This staining process is used to differentiate bacteria into two main groups. Gram-positive bacteria have a thick peptidoglycan layer in the bacterial cell wall that retains the crystal violet stain after it is washed away. These cells will appear purple. Gram-negative bacteria, on the other hand, cannot retain the violet stain after the decolorization step. The peptidoglycan layer of these cells is much thinner, sandwiched between an inner cell membrane and a bacterial outer membrane. As a result, they take up the counterstain of safranin and appear red/pink.
Catalase Test
A catalase test differentiates bacteria based on the presence of the enzyme catalase. This enzyme allows the organism to repair or escape the oxidative damage of hydrogen peroxide. It does this by releasing oxygen from the hydrogen peroxide, resulting in the appearance of bubbles on top of the colony being tested. A lack of bubbles will indicate a catalase-negative bacterium.
Oxidase Test
An oxidase test determines whether an organism possesses the cytochrome c oxidase enzyme. If the enzyme is present, the bacteria can use oxygen for energy production by converting oxygen to water with an electron transfer chain. These cells will stain purple on an oxidase disc. If the enzyme is not present, they can’t use oxygen for energy production, or they employ a different cytochrome for transferring electrons to oxygen.
